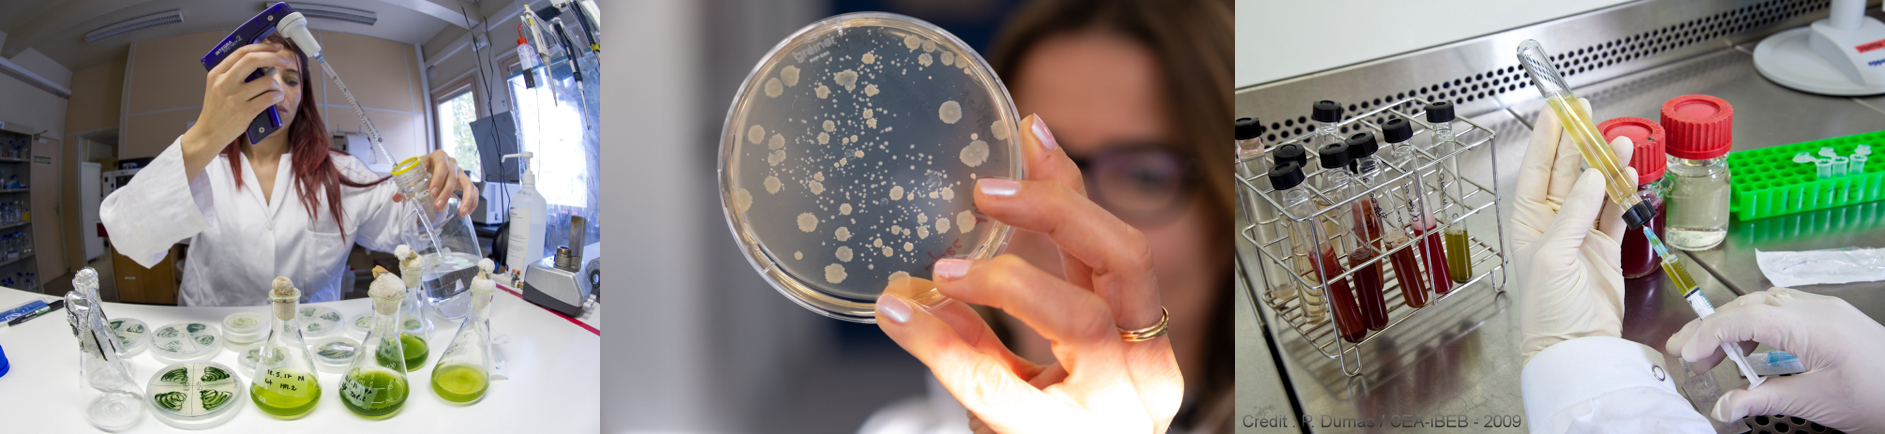

Biotechnologies Jaunes et microbiologie environnementale
4 ECTS / 28 heures de cours (CM – APP – Présentation d’articles) et une journée de visite
Autres intervenants : Frédéric Beisson, Catherine Berthomieu, Virginie Chapon et David Ranava.
L’UE Biotechnologies Jaunes et microbiologie environnementale fait partie du Semestre 3 du Parcours Ingénierie et Biotechnologies Microbiennes. Elle est dispensée par des enseignants-chercheurs et chercheurs d’Aix-Marseille Université, du CEA et du CNRS.
L’UE traite des approches scientifiques développées actuellement pour répondre à de grands enjeux sociétaux tels que la surveillance et la protection de l’environnement ou le développement de biocarburants. Au travers de cours, études d’articles et apprentissages par problème (APP), les étudiants découvrent et comprennent comment l’acquisition de connaissances fondamentales, au niveau moléculaire, cellulaire et physiologique, sur divers types de micro-organismes permet de concevoir puis développer des biotechnologies utilisables dans le domaine de l’environnement.
Trois grands thèmes sont couverts :
- Les Bioénergies
- La Bioremédiation
- Les Biocapteurs
Les enseignements sont complétés par une journée de visite de la Cité des énergies au CEA de Cadarache https://www.cite-des-energies.fr/.

The Yellow Biotechnologies and Environmental Microbiology course is part of Semester 3 of the Parcours Ingénierie et Biotechnologies Microbiennes. It is taught by lecturers and researchers from Aix-Marseille University, CEA and CNRS.
The course covers the scientific approaches currently developed to meet major societal challenges such as environmental monitoring and protection, or the development of biofuels. Through lectures, article studies and problem-based learning (PBL), students discover and understand how the acquisition of fundamental knowledge, at the molecular, cellular and physiological levels, of various types of micro-organisms enables the design and development of biotechnologies that can be used for environmental applications. Three major themes are covered:
- Bioenergies
- Bioremediation
- Biosensors
The courses are complemented by a day’s visit to the Cité des Energies at CEA Cadarache https://www.cite-des-energies.fr/







